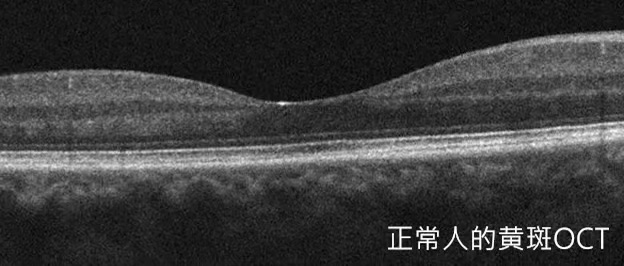
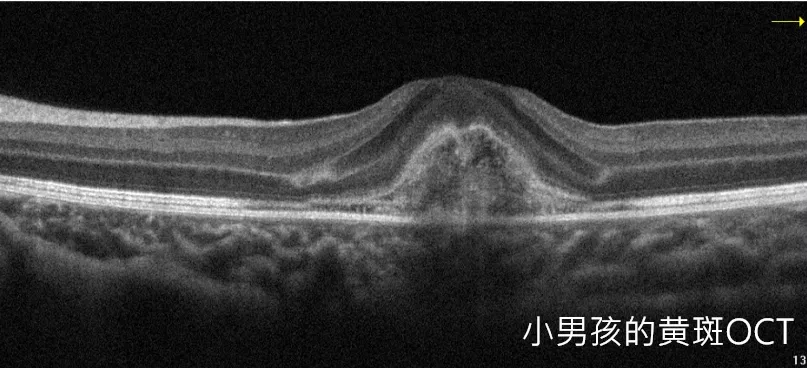

春节期间,小朋友们都在家欢度假期,新玩具也特别多。但最近有一个病例,让眼科医生特别揪心,所以特别提醒各位家长,赶紧回家找找有没有这种“玩具”,稍有不慎就是伤害眼睛的“元凶”。
前几日,七岁的男孩乐乐(化名)在家玩得好好的,突然高喊:“妈妈,我的眼睛看不见了!”妈妈听到后心里“咯噔”一下,一家人紧张起来,立刻来到苏北人民医院眼科就诊。
来到医院,妈妈仍惊魂未定:“医生,不知道怎么回事,我家孩子眼睛突然看不见了。”
医生询问道:“当时孩子在干什么?”妈妈仔细回想,原来当时孩子在玩激光笔。
眼科医生检查发现,原来小男孩的“黄斑”出现了问题。
什么是黄斑?眼科医生陈曦解释,黄斑是眼睛里的视网膜上的一个部位,因为黄斑区富含叶黄素,比周围视网膜颜色暗些,故此得名。黄斑中央的凹陷称为中央凹,是视力最敏锐的地方。如果黄斑出问题了,那么视力必然会受到严重损伤。

“我们可以明显看到,红圈圈中有一块红色的出血灶,并且正是位于小男孩的黄斑区,于是我们又进行了OCT检查。”陈曦说,OCT这项检查相当于放大镜的作用,可以更加清楚地观察到黄斑区的情况。医生发现,小男孩的黄斑区竟然长了一大块病灶。原来这就是导致小男孩看不见的原因,而激光笔正是造成这一切的元凶。

乐乐家长很疑惑,小小激光笔真的有那么大的破坏力吗?眼科医生表示,激光笔甚至会导致失明。
“许多儿童及家长对激光笔的认识不足,还有的会把激光笔当作玩具随意玩耍。”陈曦解释,尽管大多数小功率(<5mW)的激光笔,一般不会对眼睛产生危害,但如果操作不当,如直接照射人眼,就可造成视网膜的损伤。而较大功率(>5mW)的激光笔,即使是瞬间照射,也可能发生严重的视网膜损伤。
为了避免同样的悲剧再次发生,苏北医院眼科提醒,如果发生了激光笔对眼睛的损害,一定要及时就医,切莫拖延。此外,有几个注意事项要告诉各位家长:
1.不能直视激光光束;
2.不能将激光笔指向他人;
3.不能将激光笔指向反射性界面,如镜子、玻璃;
4.注意识别标识,如“注意激光辐射”;
5.尽量不要让儿童使用激光笔;
6.卫生专业人员、老师和家长应教育儿童了解激光笔的危害。
(来源:扬州发布 编辑:陈茜)








 公安备案号:32010202010067
公安备案号:32010202010067